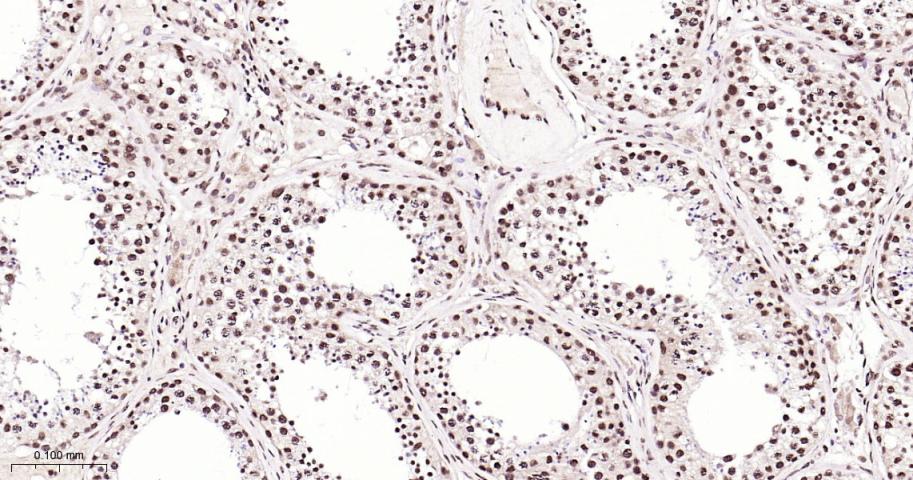
核有丝分裂器NuMA蛋白重组兔单抗

核有丝分裂器NuMA蛋白重组兔单抗
Rrmab?兔单抗

货号:bsm-61733R
产品详情
相关标记
相关产品
相关文献
常见问题
概述
产品编号
bsm-61733R
产品类型
重组兔单抗
英文名称
NUMA1 Recombinant Rabbit mAb
中文名称
核有丝分裂器NuMA蛋白重组兔单抗
英文别名
NMP-22; NUMA; NUMA1_HUMAN; NUMA1; Nuclear matrix protein-22 (NMP-22); Nuclear mitotic apparatus protein (NuMA protein); SP-H antigen; NMP22;
抗体来源
Rabbit
免疫原
KLH conjugated synthetic peptide derived from human NUMA1
亚型
IgG
性状
Liquid
纯化方法
affinity purified by Protein A
克隆类型
Recombinant
克隆号
10G4
理论分子量
238 kDa
检测分子量
238 kDa
储存液
0.01M TBS (pH7.4) with 1% BSA, 0.02% Proclin300 and 50% Glycerol.
研究领域
SWISS
Gene ID
保存条件
Store at 4℃ for short term. Store at -20℃ for long term. Avoid repeated freeze/thaw cycles.
注意事项
This product as supplied is intended for research use only, not for use in human, therapeutic or diagnostic applications.
产品介绍
NuMA (Nuclear mitotic apparatus protein)是细胞核基质中的一种高分子量蛋白质,具有一个特殊的细胞周期依赖性.核有丝分裂器蛋白NuMA与人类肿瘤细胞的恶性增殖相关.
背景资料
Microtubule (MT)-binding protein that plays a role in the formation and maintenance of the spindle poles and the alignement and the segregation of chromosomes during mitotic cell division.Functions to tether the minus ends of MTs at the spindle poles, which is critical for the establishment and maintenance of the spindle poles

产品应用
| 应用 | 已检合格种属 | 预测种属 | 推荐稀释比例 |
|---|---|---|---|
| WB | Human | Mouse, Rat | 1:500-2000 |
| IHC-P | Human, Mouse, Rat | 1:100-500 | |
| IHC-F | Human, Mouse, Rat | 1:100-500 | |
| IF | Human, Mouse, Rat | 1:100-500 | |
| Flow-Cyt | Human | Mouse, Rat | 1μg/Test |
| ICC/IF | Human | Mouse, Rat | 1:50-200 |
| ELISA | Human, Mouse, Rat | 1:5000-20000 |
交叉反应
交叉反应: Human, Mouse, Rat
相关产品
暂无相关产品
靶标
基因名
NUMA1
蛋白名
Nuclear mitotic apparatus protein 1
亚基
Homodimer. Also forms multiarm oligomers by association of C-terminal tail domains, oligomers may further assemble to form a hexagonal nuclear lattice-like network. Interacts with TNKS.
亚细胞定位
Nucleus matrix. Chromosome. Cytoplasm, cytoskeleton, spindle pole. Note=Resides in the nuclear matrix during interphases. Dissociates from condensing chromosomes during early prophase, and relocates to the spindle poles via dynein/dynamin association, it remain there until the anaphase onset. Before the complete disintegration of the nuclear lamina. As mitosis progresses it reassociates with telophase chromosomes very early during nuclear reformation, before substantial accumulation of lamins on chromosomal surfaces is evident.
Isoform Numa-m: Cytoplasm. Note=Mainly clustered at the centrosomal region.
Isoform Numa-s: Cytoplasm. Note=Mainly clustered at the centrosomal region.
Isoform Numa-m: Cytoplasm. Note=Mainly clustered at the centrosomal region.
Isoform Numa-s: Cytoplasm. Note=Mainly clustered at the centrosomal region.
翻译后修饰
ADP-ribosylated by TNKS during mitosis.
Phosphorylated in the C-terminal tail during mitosis, probably by CDK1. Phosphorylation increases solubility and promotes association with dynein and subsequent translocation to the spindle poles.
Phosphorylated in the C-terminal tail during mitosis, probably by CDK1. Phosphorylation increases solubility and promotes association with dynein and subsequent translocation to the spindle poles.
功能
Highly abundant component of the nuclear matrix where it may serve a non-mitotic structural role, occupies the majority if the nuclear volume. Required for maintenance and establishment of the mitotic spindle poles, functionning as a tether linking bulk microtubules of the spindle to centrosomes. May be involved in coordination of the alignment of the mitotic spindle to the cellular polarity axis, which is a prerequisite for asymmetric cell divisions.
标记抗体
暂无标记数据
同靶标产品
暂无同靶标产品
相关文献
提示: 发表研究结果有使用 bsm-61733R 时请让我们知道,以便我们可以引用参考文章。作为回馈,资料提供者将获得我们送上的小礼品。
暂无相关文献
常见问题
暂无常见问题